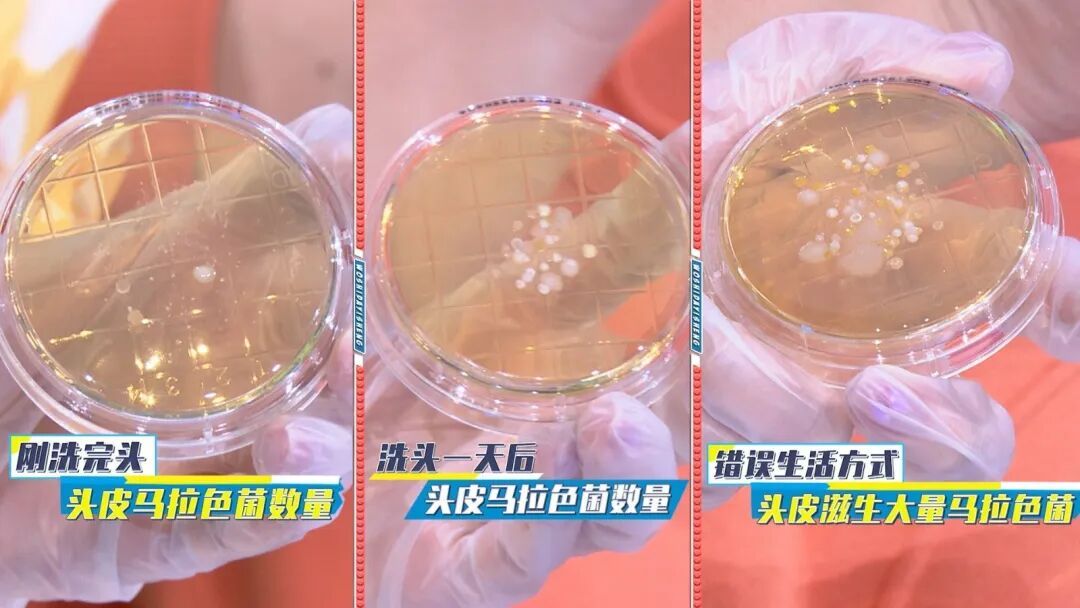
戴帽子或造成脱发?注意这几点 戴帽子或造成脱发?注意这几点

记者在北京国贸地铁站附近架起手机记录30分钟内经过的戴帽子人群,30分钟内竟有106人次戴着帽子经过,可见戴帽子,已然成为很多时尚人士的减龄时尚秘诀,棒球帽、针织帽、皮帽、毛呢帽等款式多种多样,但是你知道吗?戴帽子竟然可能是造成脱发的元凶之一?!

《我是大医生》节目现场实验实证!分别在三个不同时段,从同一位志愿者头顶上,进行真菌取样培养。实验结果发现,刚刚洗过头的头顶,真菌的培养数量相对较少,洗过头24小时之后,头顶上真菌的数量也相对偏少,但戴了8个小时帽子后,头顶的真菌取样数量大大增加!而这个由于戴帽子而引发大量繁殖的真菌,可能是诱发脱发的元凶之一——马拉色菌!
中日医院毛发医学中心的杨顶权医生提到:长时间戴帽子,会引发头皮油脂分泌过多,而马拉色菌,正是寄生在头皮上,以头皮油脂为“食物”的真菌。马拉色菌的大量繁殖,会引发头皮屏障破坏,出现脂溢性皮炎,最后引发严重的脂溢性脱发。所以日常戴帽子,一定要注意戴帽时长,切勿持续戴一整天,诱发马拉色菌的爆发性繁殖!


科学戴帽注意这几个关键要点:
1. 选对帽子
材质:优先选棉质、网布、速干面料,远离化纤。
松紧:以能轻松放入一根手指为宜,优先选带调节扣的款式。
类型:宽檐帽(如渔夫帽)比棒球帽对头部压迫更小。
2.控制时长:连续戴帽不超3小时,运动后及时摘帽。

转自:我是大医生
点击右上角
微信好友
朋友圈

点击浏览器下方“
”分享微信好友Safari浏览器请点击“
”按钮

点击右上角
QQ

点击浏览器下方“
”分享QQ好友Safari浏览器请点击“
”按钮
